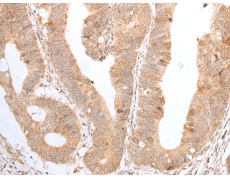
一抗

中文名稱:兔抗ZNF346多克隆抗體
|
Background: |
The protein encoded by this gene is a nucleolar, zinc finger protein that preferentially binds to double-stranded (ds) RNA or RNA/DNA hybrids, rather than DNA alone. Mutational studies indicate that the zinc finger domains are not only essential for dsRNA binding, but are also required for its nucleolar localization. The encoded protein may be involved in cell growth and survival. It plays a role in protecting neurons by inhibiting cell cycle re-entry via stimulation of p21 gene expression. Alternative splicing of this gene results in multiple transcript variants. |
|
Applications: |
ELISA, WB, IHC |
|
Name of antibody: |
ZNF346 |
|
Immunogen: |
Full length fusion protein |
|
Full name: |
zinc finger protein 346 |
|
Synonyms: |
JAZ; Zfp346 |
|
SwissProt: |
Q9UL40 |
|
ELISA Recommended dilution: |
5000-10000 |
|
IHC positive control: |
Human gastric cancer |
|
IHC Recommend dilution: |
30-150 |
|
WB Predicted band size: |
33 kDa |
|
WB Positive control: |
Human left kidney tissue lysate |
|
WB Recommended dilution: |
200-1000 |


 購物車
購物車 幫助
幫助
 021-54845833/15800441009
021-54845833/15800441009